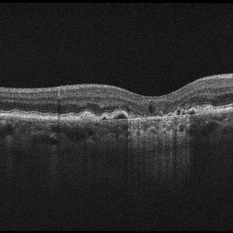

-
Multiple Acute Embolic Branch Retinal Artery Occlusions
May 27 2015 by Darin R. Goldman, MD
60-year-old phakic male with multiple retinal emboli found to have a patent foramen ovale, which was repaired surgically with no further retinal occlusive episodes.
Condition/keywords: branch retinal artery occlusion (BRAO), cherry red spot, embolus, retinal microembolism
-
Total Rhegmatogenous Retinal Detachment With Severe PVR
May 27 2015 by Darin R. Goldman, MD
63-year-old pseudophakic male with hand motion vision in the left eye due to a total retinal detachment with severe proliferative vitreoretinopathy.
Condition/keywords: proliferative vitreoretinopathy (PVR), retinal tear
-
OD Choroidal Tumor CF2
Oct 14 2015 by Darin R. Goldman, MD
55-year-old female with multiple prior primary systemic cancers. She presented with a choroidal tumor, felt to be a primary choroidal melanoma, that had ruptured Bruch's membrane, causing subretinal hemorrhage.
-
 Coats' Disease
Coats' Disease
Nov 30 2018 by Darin R. Goldman, MD
58-year-old male with a Coats’-like process in his right eye. The patient has undergone both laser photocoagulation and anti-VEGF therapy.
Photographer: Harold Rodriguez, CMA, Retina Group of Florida
Imaging device: Optomap color image, fluorescein angiogram, and fundus autofluorescence
Condition/keywords: Coats' disease, macroaneurysm, serous retinal detachment, subretinal hemorrhage
-
Leukemic Retinopathy
Jul 11 2019 by Robert A Lalane, MD
55-year-old male currently undergoing chemotherapy for leukemia. Found to have extensive retinal hemorrhaging throughout various retinal layers bilaterally.
Photographer: Brandy Maxwell, Retina Group of Florida
Condition/keywords: leukemia, retinal hemorrhage
-
Geographic Atrophy in Dry AMD
Geographic Atrophy in Dry AMD
Dec 12 2019 by Darin R. Goldman, MD
This OCT B-scan shows geographic atrophy (GA) in dry age-related macular degeneration. There is focal atrophy of the RPE and outer retinal layers underneath the fovea, which is typical of GA. The loss of RPE in the affected area, relative to the surrounding macula, results in reverse shadowing within the underlying choroid. This effect is due to more penetration of the optical signal from the OCT illumination source owing to a relative absence of light being reflected as it normally would be from intact RPE. The result is a distinct border on each side of the affected area, where the underlying choroidal signal is more intense than the immediately adjacent areas. Additionally, adjacent to the area of GA are typical drusen, which are nodule-like diffusely hyperreflective accumulations within and under the RPE/Bruch complex, and pigment epithelial detachments (PEDs), which are nodule-like elevations of the RPE with underlying hyporeflective spaces.
Condition/keywords: dry age-related macular degeneration (dry AMD), geographic atrophy, optical coherence tomography (OCT)

A project from the American Society of Retina Specialists